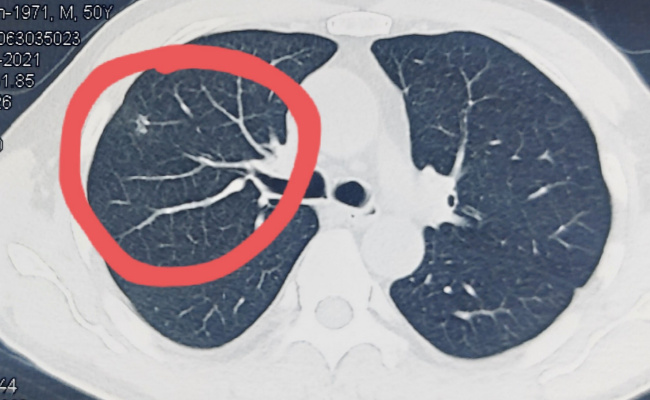

人长期暴露于石棉等物质中,引起免疫反应和炎症反应,导致肺结节。肺结节属于呼吸系统疾病,肺结节的症状有:咳嗽,胸痛,呼吸困难,咯血。肺结节并不一定都是恶性的。当患...
肺结节的症状有什么肺结节病因是什么, 长期接触石棉等物质引起免疫和炎症反应,导致肺结节。肺结节是呼吸道疾病,肺结节的症状有:咳嗽、胸痛、呼吸困难、咯血。

并非所有的肺结节都是恶性的。当患者查出肺结节时,很多人会非常担心是不是肺癌或者其他严重疾病。大多数肺结节不是恶性肿瘤,而是良性的。据研究,大约95%的肺结节是良性的,只有大约5%是恶性的。
患者及时就诊,做进一步的检查和评估,从而明确诊断,制定合适的治疗方案,是非常重要的。
肺结节的大小也是一个需要注意的重要细节。根据肺结节的直径,可分为小结节、中结节和大结节。直径小于3毫米的肺结节通常被认为是良性的,恶性肿瘤的风险较低。
而直径大于8 mm的肺结节更容易引起人们的关注和重视。为了早期发现任何异常,跟踪肺结节大小的变化是非常重要的。

肺结节的位置也是我们可能忽略的细节之一。肺结节可位于肺的各个部位,如上叶、下叶、胸膜等。病变的位置可能会影响诊断和治疗计划。例如,如果结节位于胸膜上方,可能需要胸腔镜检查或其他进一步的手术。
在评估肺结节时,必须考虑其位置,并结合其他临床症状和影像学结果,才能做出最准确的诊断。
家族史和个体差异也是需要考虑的微妙细节。有些人患有一些遗传性疾病,如结节性硬化症,可能会增加肺结节的风险。不同个体的免疫系统和遗传特征也可能导致对接触石棉和其他物质的不同反应。
在评估肺结节时,了解个体的疾病风险和家族史对于诊断和治疗的决策非常重要。
通过综合考虑这些细节,我们可以更准确地诊断和治疗肺结节,并为患者提供更好的护理。
肺结节的症状有什么肺结节病因是什么,以上就是本文为您收集整理的肺结节的症状有什么肺结节病因是什么最新内容,希望能帮到您!更多相关内容欢迎关注。
 白夜极光塔塔觉醒要什么材料
白夜极光塔塔觉醒要什么材料
 立冬后能钓鱼吗冬天不能钓鱼吗(立冬以后钓鱼钓深还是钓浅)
立冬后能钓鱼吗冬天不能钓鱼吗(立冬以后钓鱼钓深还是钓浅)
 阴茎短小怎么治最好(阴茎短小怎么治最好)
阴茎短小怎么治最好(阴茎短小怎么治最好)
 博德之门3基础属性敏捷有什么(博德之门3有什么办法增加敏捷)
博德之门3基础属性敏捷有什么(博德之门3有什么办法增加敏捷)
 《张津瑜 vs吕总卫生间》:情境对决,创意无限!
《张津瑜 vs吕总卫生间》:情境对决,创意无限!
 绿巨人下载安装无限看
绿巨人下载安装无限看
绿巨人下载安装无限看-丝瓜ios这里有着超高颜值的视频内容,大家都能够去尽情的选择自己喜...
 博得之门3驱散不死生物是什么效果(博得之门3驱散不死生物是什么效果)
博得之门3驱散不死生物是什么效果(博得之门3驱散不死生物是什么效果)
《博德之门3》是拉瑞安推出的一款角色冒险游戏,游戏最近新上线了正式版本。驱散不死生物...
 创造与魔法金龙鱼用什么钓
创造与魔法金龙鱼用什么钓
为你提供关于创造与魔法的信息,咱就是说一款有开放世界、卡通、养成、冒险的游戏有几个...
 遗迹2永恒地平线怎么去(遗迹2灰烬重生)
遗迹2永恒地平线怎么去(遗迹2灰烬重生)
《遗迹2》中的永恒地平线地图是游戏里非常重要的一个地方,开场的追寻者休憩处的就是永恒...
 博德之门3涟漪之力锁甲怎么获得(博德之门3蘸取)
博德之门3涟漪之力锁甲怎么获得(博德之门3蘸取)
《博德之门3》是拉瑞安推出的一款角色冒险游戏,游戏最近新上线了正式版本。涟漪之力锁甲...